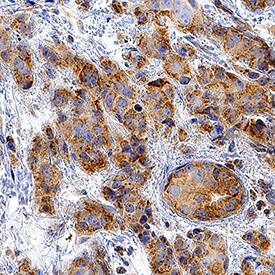
CXCR7/RDC-1 antibody in Human Breast Cancer Tissue by Immunohistochemistry (IHC-P).

Human CXCR7/RDC-1 Antibody
R&D Systems, part of Bio-Techne | Catalog # MAB4227R


Key Product Details
Species Reactivity
Applications
Label
Antibody Source
Product Specifications
Immunogen
Met1-Lys362 (Gly131Ser)
Accession # AAA62370
Specificity
Clonality
Host
Isotype
Scientific Data Images for Human CXCR7/RDC-1 Antibody
Detection of CXCR7/RDC‑1 in Human peripheral blood Monocytes by Flow Cytometry.
Human peripheral blood monocytes were stained with Mouse Anti-Human CXCR7/RDC-1 Monoclonal Antibody (Catalog # MAB4227R, filled histogram) or isotype control antibody (Catalog # MAB003, open histogram), followed by APC-conjugated Anti-Mouse IgG F(ab')2 Secondary Antibody (Catalog # F0101B). View our protocol for Staining Membrane-associated Proteins.Detection of CXCR7/RDC‑1 in HEK293 Human Cell Line Transfected with Human CXCR7/RDC-1 and eGFP by Flow Cytometry.
HEK293 human embryonic kidney cell line transfected with human CXCR7/RDC-1 and eGFP was stained with (A) Mouse Anti-Human CXCR7/RDC-1 Monoclonal Antibody (Catalog # MAB4227R) followed by APC-conjugated Anti-Mouse IgG Secondary Antibody(Catalog # F0101B). Quadrant markers were set based on control antibody staining (Catalog # MAB003). View our protocol for Staining Membrane-associated Proteins.CXCR7/RDC‑1 in Human Breast Cancer Tissue.
CXCR7/RDC-1 was detected in immersion fixed paraffin-embedded sections of human breast cancer tissue using Mouse Anti-Human CXCR7/RDC-1 Monoclonal Antibody (Catalog # MAB4227R) at 0.5 µg/mL for 1 hour at room temperature followed by incubation with the Anti-Mouse IgG VisUCyte™ HRP Polymer Antibody (Catalog # VC001). Tissue was stained using DAB (brown) and counterstained with hematoxylin (blue). Specific staining was localized to cytoplasm. View our protocol for IHC Staining with VisUCyte HRP Polymer Detection Reagents.Applications for Human CXCR7/RDC-1 Antibody
CyTOF-ready
Flow Cytometry
Sample: Human peripheral blood monocytes and HEK293 Human Cell Line Transfected with Human CXCR7/RDC-1
Immunohistochemistry
Sample: Immersion fixed paraffin-embedded sections of human breast cancer tissue
Formulation, Preparation, and Storage
Purification
Reconstitution
Formulation
Shipping
Stability & Storage
- 12 months from date of receipt, -20 to -70 °C as supplied.
- 1 month, 2 to 8 °C under sterile conditions after reconstitution.
- 6 months, -20 to -70 °C under sterile conditions after reconstitution.
Background: CXCR7/RDC-1
The G protein-coupled receptor, RDC1, belongs to a subgroup of chemokine receptors and has been designated CXCR7. CXCR7 can bind with high-affinity to CXCL12/SDF-1 and CXCL11/I-TAC. It is also a co-receptor for several HIV and SIV strains. In their N-termini and extracellular loops 1, 2, and 3, human and mouse CXCR7 share 84%, 100%, 96% and 86% amino acid sequence identity, respectively. Reports of mRNA levels and/or protein expression (as assessed using anti‑CXCR7, clone 9C4) (1, 2) indicate that CXCR7 occurs on a wide variety of tissues and cells including monocytes, B cells, T cells and mature dendritic cells. In contrast, based on ligand binding analysis and receptor level (as assessed using anti‑CXCR7, clone 11G8), surface expression of CXCR7 was reported to be restricted to tumor cells, activated endothelial cells, fetal liver cells, and few other cell types (3). The basis of these inconsistent observations is not known but may be attributed to cell context and the use of different antibodies that may recognize different epitopes.
References
- Balabanian, K. et al. (2005) J. Biol. Chem. 280:35760.
- Infantino, S. et al. (2006) J. Immunol. 176:2197.
- Burns, J.M. et al. (2006) J. Exp. Med. 203:2201.
Alternate Names
Gene Symbol
UniProt
Additional CXCR7/RDC-1 Products
Product Documents for Human CXCR7/RDC-1 Antibody
Product Specific Notices for Human CXCR7/RDC-1 Antibody
For research use only